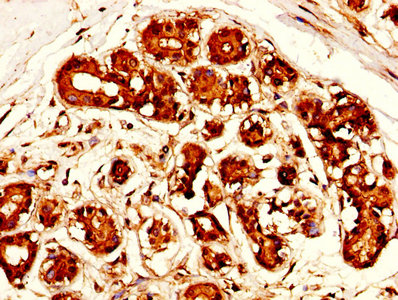

MSLN Antibody
-
中文名稱:MSLN兔多克隆抗體
-
貨號:CSB-PA10159A0Rb
-
規格:¥440
-
圖片:
-
IHC image of CSB-PA10159A0Rb diluted at 1:300 and staining in paraffin-embedded human ovarian cancer performed on a Leica BondTM system. After dewaxing and hydration, antigen retrieval was mediated by high pressure in a citrate buffer (pH 6.0). Section was blocked with 10% normal goat serum 30min at RT. Then primary antibody (1% BSA) was incubated at 4°C overnight. The primary is detected by a biotinylated secondary antibody and visualized using an HRP conjugated SP system.
-
IHC image of CSB-PA10159A0Rb diluted at 1:300 and staining in paraffin-embedded human breast cancer performed on a Leica BondTM system. After dewaxing and hydration, antigen retrieval was mediated by high pressure in a citrate buffer (pH 6.0). Section was blocked with 10% normal goat serum 30min at RT. Then primary antibody (1% BSA) was incubated at 4°C overnight. The primary is detected by a biotinylated secondary antibody and visualized using an HRP conjugated SP system.
-
Immunofluorescence staining of Hela cells with CSB-PA10159A0Rb at 1:100, counter-stained with DAPI. The cells were fixed in 4% formaldehyde, permeabilized using 0.2% Triton X-100 and blocked in 10% normal Goat Serum. The cells were then incubated with the antibody overnight at 4°C. The secondary antibody was Alexa Fluor 488-congugated AffiniPure Goat Anti-Rabbit IgG(H+L).
-
Immunoprecipitating MSLN in HepG2 whole cell lysate
Lane 1: Rabbit control IgG instead of CSB-PA10159A0Rb in HepG2 whole cell lysate. For western blotting, a HRP-conjugated Protein G antibody was used as the secondary antibody (1/2000)
Lane 2: CSB-PA10159A0Rb (8µg) + HepG2 whole cell lysate (500µg)
Lane 3: HepG2 whole cell lysate (10µg)
-
-
其他:
產品詳情
-
產品名稱:Rabbit anti-Homo sapiens (Human) MSLN Polyclonal antibody
-
Uniprot No.:
-
基因名:
-
別名:CAK 1 antibody; CAK1 antibody; CAK1 antigen antibody; cleaved form antibody; Megakaryocyte potentiating factor antibody; Mesothelin antibody; Mesothelin isoform 1 precursor antibody; MPF antibody; Msln antibody; MSLN_HUMAN antibody; Pre pro megakaryocyte potentiating factor antibody; Pre-pro-megakaryocyte-potentiating factor antibody; SMR antibody; SMRP antibody; Soluble MPF mesothelin related protein antibody
-
宿主:Rabbit
-
反應種屬:Human
-
免疫原:Recombinant Human Mesothelin protein (37-598AA)
-
免疫原種屬:Homo sapiens (Human)
-
標記方式:Non-conjugated
本頁面中的產品,MSLN Antibody (CSB-PA10159A0Rb),的標記方式是Non-conjugated。對于MSLN Antibody,我們還提供其他標記。見下表:
-
克隆類型:Polyclonal
-
抗體亞型:IgG
-
純化方式:>95%, Protein G purified
-
濃度:It differs from different batches. Please contact us to confirm it.
-
保存緩沖液:Preservative: 0.03% Proclin 300
Constituents: 50% Glycerol, 0.01M PBS, PH 7.4 -
產品提供形式:Liquid
-
應用范圍:ELISA, IHC, IF, IP
-
推薦稀釋比:
Application Recommended Dilution IHC 1:200-1:500 IF 1:50-1:200 IP 1:200-1:2000 -
Protocols:
-
儲存條件:Upon receipt, store at -20°C or -80°C. Avoid repeated freeze.
-
貨期:Basically, we can dispatch the products out in 1-3 working days after receiving your orders. Delivery time maybe differs from different purchasing way or location, please kindly consult your local distributors for specific delivery time.
-
用途:For Research Use Only. Not for use in diagnostic or therapeutic procedures.
相關產品
靶點詳情
-
功能:Membrane-anchored forms may play a role in cellular adhesion.; Megakaryocyte-potentiating factor (MPF) potentiates megakaryocyte colony formation in vitro.
-
基因功能參考文獻:
- Elevated plasma MSLN level is related with epithelial ovarian cancer. PMID: 30319054
- We have demonstrated that a rising serum mesothelin is a sensitive marker of progression in the follow up of patients with MPM. PMID: 29454314
- we engineered variants of the fibronectin type III domain (Fn3) non-antibody protein scaffold to bind to mesothelin with high affinity, using directed evolution and yeast surface display PMID: 29738555
- Our goal was to stimulate antitumor immunity by combining SS1P or LMB-100 with anti-CTLA-4. We constructed a BALB/c breast cancer cell line expressing human mesothelin (66C14-M), which was implanted in one or two locations. SS1P or LMB-100 was injected directly into established tumors and anti-CTLA-4 administered i.p. In mice with two tumors, one tumor was injected with immunotoxin and the other was not. PMID: 28674083
- Mesothelin-targeted immunotoxin RG7787 increases pancreatic cancer cell sensitivity to taxane-mediated killing by increasing taxane-mediated microtubule stability and priming cells for apoptosis by decreasing levels of the pro-survival factor Mcl-1. PMID: 27999204
- RG7787 plus nab-paclitaxel is very active against primary human mesothelioma cells in vitro as well as in vivo, with serum mesothelin levels correlating with tumor response. These results indicate that this combination could be useful for treating patients with mesothelioma PMID: 27635089
- Efficient growth suppression in pancreatic cancer PDX model by fully human anti-mesothelin CAR-T cells. PMID: 28929447
- Mesothelin/mucin 16 signaling in activated portal fibroblasts regulates cholestatic liver fibrosis.( PMID: 28287406
- MiR-21-5p is suggested as novel regulator of MSLN with a possible functional role in cellular growth. PMID: 28125734
- we report herein that high tumor mesothelin expression predicts a shorter PFS and OS in EOC patients and demonstrates that serum mesothelin predicts local tumor mesothelin expression. PMID: 28160193
- We provide new evidence for the role of MSLN in EMT regulation, tumorigenesis and metastasis. Knockdown of MSLN led to mesenchymal to epithelial transition and less aggressive behavior of lung carcinoma and mesothelioma cells. PMID: 28288645
- MSLN expression increases cell migration and invasion in vitro. PMID: 27422997
- SMRP but not FBLN3 has a role in pleural effusions in in malignant pleural mesothelioma PMID: 28314308
- High mesothelin expression is associated with malignant pleural mesothelioma. PMID: 27646775
- Calretinin, D2-40 and mesothelin are aberrantly expressed in a proportion of CRC cases. PMID: 27062033
- Our results showed that IMP3 immunostaining has a higher sensitivity and specificity than mesothelin for the diagnosis of pancreatic ductal adenocarcinoma. IMP3 and mesothelin may be useful markers in distinguishing neoplastic from reactive lesions of the pancreas in instances where this is impossible by morphology alone in surgical pathology practice. PMID: 26874572
- Results indicate a specific mesothelin-driven tumor uptake of targeted 89zirconium-labeled antibody which visualizes mesothelin expressing pancreatic cancer in real time. PMID: 26536664
- Data indicate that triple-negative breast cancer (TNBC) showed the highest amplification rate (42%) in the basal-like 1 subtype. PMID: 26172299
- There was a trend toward elevation of SMRP values in healthy individuals exposed to asbestos compared to those without exposure. Within asbestosis cases, those with higher profusion scores had higher SMRP values than those with lower profusion scores. PMID: 26188910
- High mesothelin expression was strongly associated with mutant KRAS/wild-type EGFR and poor prognosis in advanced lung cancer. PMID: 26028668
- findings replicate association between rs1057147 and soluble mesothelin related peptide(SMRP)levels; SMRP performance as diagnostic biomarker for malignant pleural mesothelioma improved by considering genotype rs1057147; this polymorphism most likely affects a binding site for miR-611 PMID: 25436799
- Expression of mesothelin was observed in 42.3% of patients with triple negative breast cancer. PMID: 25776500
- Patients with mesothelin-positive triple negative breast carcinomas (TNBC) were older than patients with mesothelin-negative TNBC, developed more distant metastases with a shorter interval, and had significantly lower overall and disease-free survival. PMID: 25506917
- Delivery of mesothelin-targeted CAR T cells eradicates tumors in mice with pleural malignancies. PMID: 25378643
- Pleural fluid mesothelin may serve as a marker for pleural malignant mesothelioma. PMID: 25505814
- Patients with colon cancer had significantly higher mesothelin serum levels than the control groups. PMID: 25477701
- Mesothelin expression is associated with poor outcomes in breast cancer.Mesothelin is a prognostic breast tumor marker whose expression is highly enriched in triple negative breast cancer tumors. PMID: 25193277
- A serum mesothelin level is a prognostic indicator for patients with malignant mesothelioma in routine clinical practice. PMID: 25227779
- Both the serum CA125(meso) level and the ratio of the serum CA125(mesothelin) to CA125 levels (CA125(mesothelin) /CA125) were significantly higher in patients with EOC. PMID: 25197000
- Serum IGFBP2 and MSLN are weak diagnostic classifiers individually, but may be useful in a diagnostic biomarker panel for pancreatic cancer. PMID: 24308545
- MSLN-silencing caused decreased proliferation rate and reduced invasive capacity and sphere formation in MSLN-overexpressing Mero-14 cells. PMID: 24465798
- Being negative/focally positive for mesothelin expression was associated with longer postoperative survival than positive expression in patients with cholangiocellular carcinoma. Mesothelin positivity was a predictor of short postoperative survival. PMID: 23701154
- Our findings suggest that MLSN can be used as a marker of neoplastic transformation of epithelial cells in pancreatic mucinous cysts. PMID: 25125620
- MSLN expression in patients with early-stage lung adenocarcinoma is associated with increased risk of recurrence and reduced overall survival. PMID: 24334761
- These data provides evidence for the use of mesothelin as an immunogen for tumour-specific T cell response. PMID: 24520352
- Mesothelin provokes lymphatic invasion of colorectal adenocarcinoma. PMID: 23512344
- In the gastric cancer tissues, C-ERC/mesothelin expression was associated with lymphatic invasion. N-ERC/mesothelin was secreted into the supernatants of gastric cancer cell lines, but does not appear to be a useful serum marker of gastric cancer. PMID: 24146039
- Use of S100P and mesothelin in cytologically borderline cases can increase the diagnostic accuracy for pancreatic adenocarcinoma. PMID: 21538952
- Data indicate that biochemical markers significantly associated with mesothelioma were hyaluronan, N-ERC/mesothelin and syndecan-1. PMID: 23991032
- PE-SMRP adds some clinical information in the work-up of patients with a PE of unknown origin. PMID: 23873013
- Mesothelin expression was identified in 34% of patients with triple receptor negative breast cancer. PMID: 23810431
- addition of YKL-40 may improve the specificity of mesothelin measurements alone for detecting patients with multiple myeloma PMID: 24324091
- These data suggest that in difficult diagnostic cases both PAX2 and mesothelin immunohistochemical study may be useful in discriminating between PMRCC and primary pancreatic carcinoma. PMID: 24344503
- SMRP could improve CYFRA 21-1 antigen and carcinoembryonic antigen (CEA) accuracy in the differential diagnosis of malignant pleural mesothelioma. PMID: 23532816
- Mesothelin binding to CA125/MUC16 promotes pancreatic cancer cell motility and invasion via MMP-7 activation. PMID: 23694968
- Mesothelin, megakaryocyte potentiating factor and osteopontin are expressed in malignant mesothelioma [review] PMID: 22835614
- MSLN overexpression promoted the invasive potential of MCF-7 cells through ERK1/2-dependent upregulation of MMP-9; this association may have contributed to metastasis of MCF-7 cells in vivo. PMID: 23321167
- Data indicate that binding of mesothelin to CA125 does not alter the measurement of mesothelin for the detection of malignant mesothelioma (MM). PMID: 23357461
- The mesothelin expression promotes resistance to certain chemotherapy drugs such as TNF-alpha, paclitaxel, and a combination of platinum and cyclophosphamide. PMID: 22721387
- SMRP was lower in healthy subjects than in subjects with malignant tumors, asbestos-related pleural lesions, and other benign diseases PMID: 23277285
顯示更多
收起更多
-
相關疾病:Antibodies against MSLN are detected in patients with mesothelioma and ovarian cancer.
-
亞細胞定位:Cell membrane; Lipid-anchor, GPI-anchor. Golgi apparatus.; [Megakaryocyte-potentiating factor]: Secreted.; [Isoform 3]: Secreted.
-
蛋白家族:Mesothelin family
-
組織特異性:Expressed in lung. Expressed at low levels in heart, placenta and kidney. Expressed in mesothelial cells. Highly expressed in mesotheliomas, ovarian cancers, and some squamous cell carcinomas (at protein level).
-
數據庫鏈接:
Most popular with customers
-
-
YWHAB Recombinant Monoclonal Antibody
Applications: ELISA, WB, IHC, IF, FC
Species Reactivity: Human, Mouse, Rat
-
Phospho-YAP1 (S127) Recombinant Monoclonal Antibody
Applications: ELISA, WB, IHC
Species Reactivity: Human
-
-
-
-
-